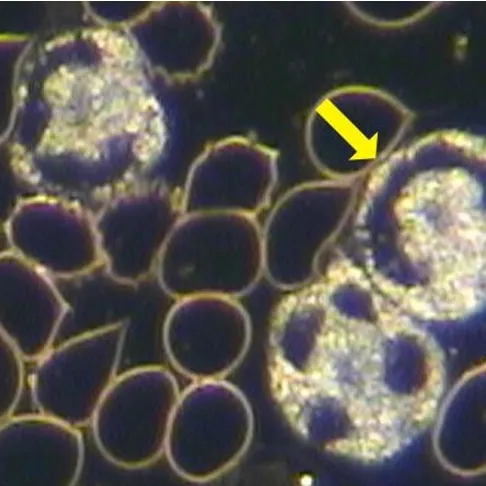
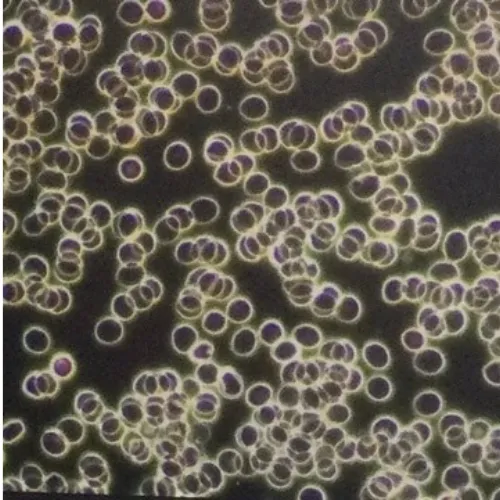

These carry oxygen and nutrients to every cell in your body. Their size, shape, and movement tell us a lot about your energy levels, nutrient absorption, hydration, and circulation. When they’re vibrant and free-flowing, your body thrives. When they’re clumped or misshapen, it can signal imbalance or stress.

These are your immune system’s warriors. By looking at their activity and numbers, we can see how your body is responding to infections, inflammation, or hidden burdens. Strong, active white cells show resilience. Weak or sluggish ones suggest your immune defenses may be compromised.
These tiny fragments are essential for clotting and circulation. Too many, too few, or irregular patterns can highlight issues with blood flow, cardiovascular stress, or even how well your body is repairing itself.

Beyond the main cell types, we often see additional markers that reveal oxidative stress, toxin buildup, yeast, or parasitic activity. These subtle signs give important clues about your terrain and where your body may need support.

Free Radical Damage → Patterns in the dried blood show the impact of oxidative stress — the cellular “wear and tear” that can accelerate aging and chronic illness.
Toxin Burden → Highlights accumulation of toxins from diet, environment, or lifestyle, helping us know when detox support is needed.
Inflammatory Patterns → Certain formations reveal chronic inflammation that may underlie many of your symptoms.
Systemic Stress → The overall “picture” of the dried blood slide can reflect how much strain your body has been under — and how resilient your terrain currently is.

Identify the root causes of your symptoms
Focus on the right dietary and lifestyle shifts
Choose effective natural modalities and protocols
Track progress over time with repeat analysis
A simple finger-prick provides a drop of blood on a glass slide.
Your live blood is viewed immediately on a screen — no drying, no staining, nothing altered.
We may also prepare a dry blood slide to assess oxidative stress and long-term toxin burden.
You’ll see your blood in real time as we review together what’s happening in your terrain.
You’ll leave with insights and recommendations tailored to your body’s unique needs.
Live and Dry Blood Analysis don’t diagnose disease.
They reveal the state of your body's inner environment— the foundation of your health.
By seeing your blood in real time, you:
→ Gain clarity about what your body is showing
→ Feel empowered to take aligned steps
→ Track your progress visually as your terrain shifts and heals
A Live Blood session gives powerful insights and can be your starting point, helping us identify where you are right now and which phase your body is ready for — but true lasting change comes from supporting your body over time. From your appointment, you get to decide whether to stay with a single session or step into a full journey of regeneration.
Many of my clients choose to continue inside Wellness Re-Engineered, my signature 4-phase program for those wanting more individualized support. This is where I walk beside you step by step through each phase of regeneration, ensuring your protocols, pace, and progress align with your body’s unique needs.
Others prefer the Wellness Re-Engineered Membership, which provides ongoing education, community support, and access to advanced tools — allowing you to move through the phases at your own pace with guidance always available.